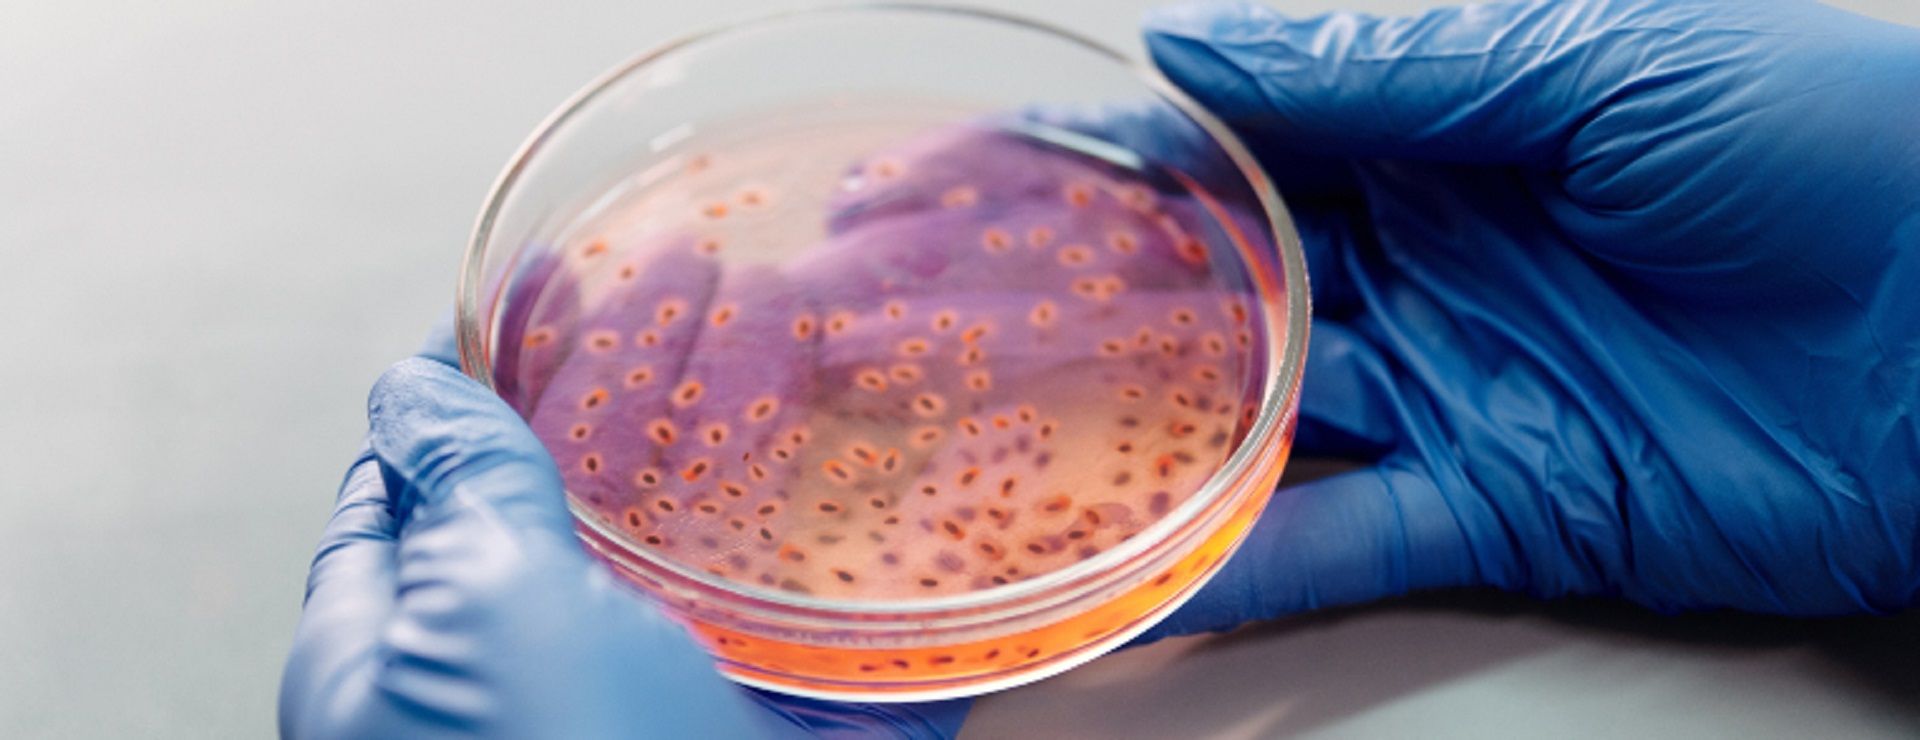
Você já ouviu falar do Candida auris?

Até o momento, 24 casos foram confirmados em todo o país, com mais de 230 em investigação. Dos casos confirmados, cinco mortes já foram atestadas, todas no estado de São Paulo. Outros 11 óbitos seguem em apuração.
NOROVÍRUS: o que é, transmissão, sintomas e tratamento
A Secretaria de Saúde de São Paulo confirmou, em 8 de janeiro, que o norovírus está causando um surto de virose no litoral de SP.
Mpox: Entenda a emergência de saúde e como se proteger
Em 14 de agosto de 2024, a OMS declarou que a Mpox é uma emergência de saúde pública internacional, em decorrência do número de casos.
7 dicas para uma boa higienização dos alimentos
Higienizar os alimentos de forma adequada previne uma série de doenças. A maior parte delas provoca apenas sintomas leves, no entanto, qualquer dor no estômago pode ser um grande incômodo.
Você já ouviu falar do Candida auris?
Busque atendimento médico imediato se tiver sintomas depois de visitar unidades de saúde ou pessoas internadas.
O que é preciso saber sobre a Febre Maculosa
A doença é causada por uma bactéria transmitida pela picada de carrapatos e, se não for tratada no início dos sintomas, pode levar à morte.
Doenças comuns do inverno e como evitá-las
Saiba mais sobre os cuidados com a saúde durante a época mais fria do ano.
O que é Varíola dos Macacos: sintomas, transmissão e prevenção
No dia 9 de junho de 2022, o Instituto Adolfo Lutz confirmou o primeiro caso de varíola dos macacos no Brasil. Pensando nisso, nossa equipe médica reuniu as principais respostas sobre a infecção. Entenda!
Mãe, você também precisa olhar para si
Afinal, a saúde materna é essencial para garantir a saúde da criança e, por extensão, de toda a família.
Câncer e alimentação: a verdade sobre essa relação
Separamos quatro questões sobre a relação entre câncer e alimentação e a verdade sobre elas.
O que você precisa saber sobre a epidemia de Gripe
Nas últimas semanas, a cidade do Rio de Janeiro tem passado por uma epidemia de gripe, o que colocou outros estados em alerta.
Saúde do homem: barreiras culturais ainda são obstáculos
Há muitos tabus em torno da masculinidade e o cuidado com a saúde é um deles.